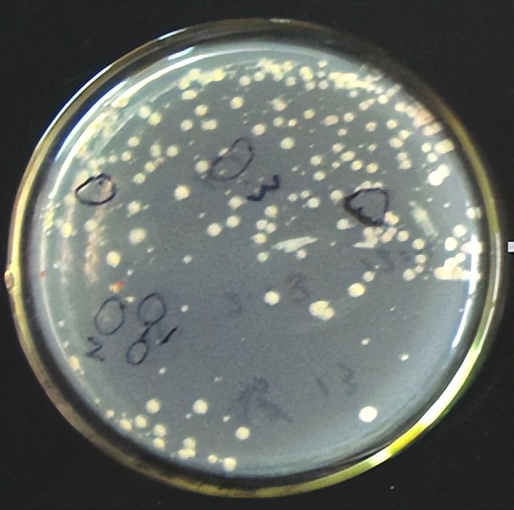
猪源链球菌的分离鉴定
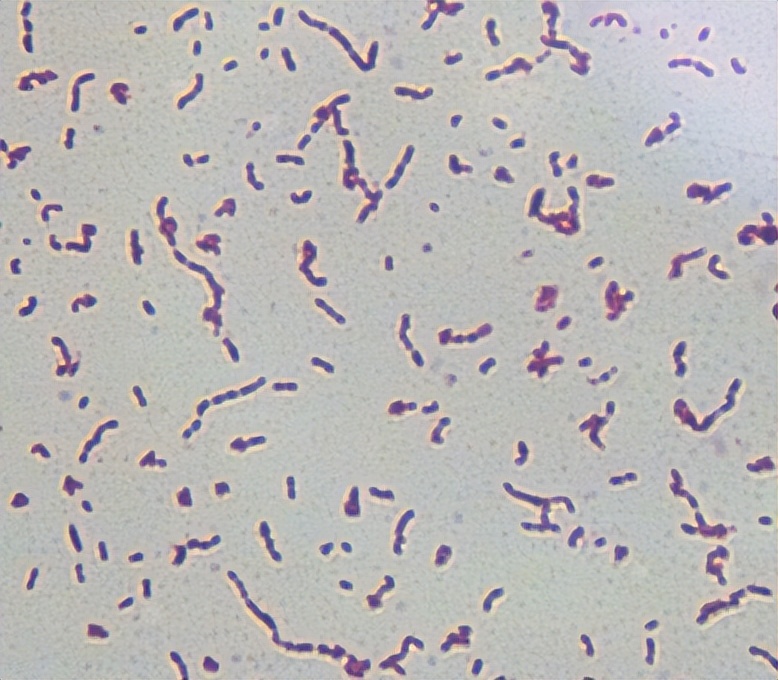
猪源链球菌的分离鉴定

猪源链球菌的分离鉴定
摘 要
猪链球菌病(streptococcicosis)是猪的一种常见传染病。2009年2月至5月,本试验从来自洛阳及周边地区患病猪采集肺脏、心血、脾脏、肝脏等病料样本并进行细菌的分离、纯化、鉴定和保藏,以了解这些地区猪链球菌的种类、数量和分布等,从而为该地区猪链球菌病的防治奠定理论基础。首先,将采集病料样本转接到加有血清和V因子的胰蛋白胨大豆琼脂(Tryptic Soy Agar, TSA)培养基上进行分离培养、纯化;然后,通过细菌生长特性、形态观察、革兰氏染色等方法进行实验室常规鉴定,并进一步对部分细菌进行PCR鉴定;最后,将所有分离鉴定的菌株进行冻干保藏和流行病学分析。结果表明:在23份有发病猪的肺脏等病料样本中,共分离出7株链球菌(19.5%)。进一步通过猪链球菌的种特异性引物进行PCR鉴定,发现有3株猪链球菌。这7株链球菌分别来自洛阳不同地区的发病猪。本研究的结果表明,在洛阳及其周边地区的猪群中,猪链球菌的感染情况非常严重,在猪链球菌病的防治过程中应当给予重视。本研究为猪链球菌病的防治提供了理论数据;同时,为猪链球菌病快速诊断试剂与高效疫苗的研制、开发等提供了菌株材料。
关键词:猪,链球菌,分离,鉴定,PCR
- 前 言
猪链球菌病(streptococcicosis)是猪的一种常见传染病。该病病症复杂,危害严重,可由不同型别的链球菌(Streptococcus)引起,如马链球菌兽疫亚种(S. equi subsp. zooepidemious)、猪链球菌(S. suis)、马链球菌亚种(S. equi subsp.equi)、类猪链球菌(S. porience)等。很长时间以来马链球菌兽疫亚种一直是我国猪链球菌病的主要病原,但这几年以来猪链球菌大有后来居上的趋势,已引起兽医界的足够重视。
- 猪链球菌
自20世纪50年代初期证实猪链球菌是猪脑膜炎、关节炎的主要病原以来,荷兰、英国、美国、加拿大、澳大利亚、新西兰、巴西、丹麦、日本、中国等先后报道了猪链球菌病。该病严重影响各国养猪业的发展,尤其是高密度的养猪场的危害更大。
- 分类
猪链球菌根据菌体荚膜抗原性的不同,可以分为35个血清型,其中2型流行最广,对猪的致病性也最强,其次是1型。Aarestrup等报道了1995~1996年丹麦的猪链球菌主要流行的血清型是2型和7型,少部分3, 4, 8型,还有占比例较低的其它一些型,发现丹麦流行的猪链球菌血清型己发生了变化[1]。Han等调查了韩国猪链球菌的流行情况,屠宰猪只分离率占13.8%,猪群分离率占48.3%,分离株有47.3%未能定型,在被确定血清型中以9型和16型为主[2]。 Berthelot-Herault等报道了从法国分离到猪链球菌2,3,7和9型。Hommez等研究了从比利时病猪分离到的链球菌,有停乳链球菌类马亚种、类猪链球菌、无乳链球菌、粪肠球菌和C02依赖性的猪链球菌[3]。Katsumi等分离鉴定了日本1985~1994年间发生心内膜炎的猪的病原链球菌,其中25.7%为猪链球菌,15.2%为停乳链球菌,猪链球菌中2型占最大比例为35.4%,9型占1%,其它61.6%未能分出血清型[4]。猪链球菌1型为S群,有的不能分群,有的属S-R群或T群,但非C群。α或β溶血,一般起先为α溶血,延时培养后则变为β溶血。或者菌落周围不见溶血,刮去菌落则可见α或β溶血。猪链球菌2型在绵羊血平板呈α溶血,马血平板则为β溶血。
- 形态及抵抗力
革兰氏阳性菌,菌落小,灰白透明,稍粘。菌体直径1 mm左右,单个或双个卵圆形,在液体培养中才呈链状。猪链球菌2型常污染环境,在粪、灰尘及水能存活较长时间。在水中该菌60°C可存活10 min,50°C为2 h,在4°C的动物尸体中可存活6周,0°C时灰尘中的细菌可存活1个月,粪中则为3个月;25°C时在灰尘和粪中则只能存活24 h及8 d。
- 毒力因子
溶菌酶释放蛋白(muramidae-relased protein, MRP)及细胞外蛋白因子(extracellular factor, EF)是猪链球菌2型的两种重要毒力因子。MRP分子量136,000,与A群链球菌的M蛋白有同源性。EF分子量110,000。从健康猪分离的菌株通常缺少这两种蛋白,而且人工感染无致病性。猪溶血素(suilysin)是一种硫激活的细胞毒素,属穿孔毒素,已证实它是有效的免疫原。猪链球菌2型欧洲分离株95%可检出此毒素基因,而北美分离株则只有7%的阳性率。另一种可能的毒力因子为IgG结合蛋白,分子量60,000,属热休克蛋白家族,可结合猪的IgG的Fc端,从而影响了抗体的活性。
- 猪链球菌病
猪链球菌病在我国流行很普遍,近年来随着集约化养猪的推广以及猪繁殖与呼吸障碍综合征和猪圆环病毒2型等疫病的流行,使本病的危害有增大的趋势.二十世纪九十年代前其病原以马链球菌兽疫亚种为主,之后其它型的发现和报道增多,尤其是猪链球菌2型流行和危害突出。1998年黄毓茂等首次报道了猪链球菌2型在我国的存在[5]。1998年7-8月间,江苏省苏中部分县市生猪发生一种急性、热性、败血性传染病,仅40余天内,该地区共有47个乡镇462个村8871个农户13472头生猪发病,死亡生猪6142头,经鉴定,其病原为猪链球菌2型,这是我国首次报道猪链球菌2型引起的大规模暴发[6]。马有智等2002年前后在浙江省某猪场从临床表现为脑膜炎、关节炎及败血症的发病猪分离到2株细菌,用猪链球菌2型、1型和9型抗血清进行凝集试验,结果所分离菌均为猪链球2型[7]。许信刚等2003年报道了从陕西某发病猪场分离到一株致病菌,经鉴定为猪链球菌2型[8]。刘佩红等1997~1999年从上海地区分离出15株猪源链球菌,用国际通用的链球菌A-G乳胶分型诊断液和猪链球菌1, 2型标准阳性血清进行检测,4株为C群链球菌,1株为2型猪链球菌,1株为B群链球菌,1株为D群链球菌,1株与A群和C群有交叉反应,7株不在其检测范围[9]。倪宏波等2000~2001年从长春地区分离到20株猪源链球菌,用国际通用的链球菌A-G乳胶分型诊断试剂盒检测,5株为C群链球菌,9株为D群链球菌,1株为G群链球菌,2株与D群和G群有交叉反应,3株不在检测范围,证实长春地区猪链球菌病的病原已不局限于原有的C群链球菌[10]。杨霞等2003年报道对来自焦作、鹿邑等八个地方的疑似链球菌病的猪病料进行分离、纯化,得到8株此菌,进行了生化分群试验。结果,这八个地方的猪病料中的链球菌中D群的有4株,H, B, C群的各1株,抗原群未被确定的I株[11]。
1998~1999年夏季在我国江苏省的猪场中先后两次爆发急性败血症,并从中分离到此菌,并出现特定人员感染致死的现象,不仅给养猪业造成严重的经济损失,也给公共卫生带来威胁,从而引起各单位的高度重视纷纷展开研究调查。猪链球菌2型已成为我国当前引起人畜共患病的一种重要的新病原菌。
- 病原特性
猪链球菌为革兰氏阳性球菌,直径小于2 um,单个、成对或成链存在,菌落细小,浅灰色或半透明,略呈粘液状。溶血性不甚明显,因菌株和培养条件而异,可表现为α或β溶血。一般能发酵乳糖和海藻糖产酸,不发酵甘露醇和山梨醇不水解马尿酸酐,但猪链球菌的生化特性往往差异很大,即使采用试剂盒作数值分类,也未必能获得特定的结果[8]。
猪链球菌的生化反应差异很大,因此必须结合血清学反应才能对其分离株进行准确定位。血清学鉴定以区别荚膜多糖抗原的差异为基础。有多种方法,包括玻片凝集试验、荚膜肿胀试验、毛细管沉淀反应和协同凝集反应等,其中协同凝集反应应用最为广泛,该法早作简单、结果可靠,只要将结合了金黄色葡萄球菌A蛋白的猪链球菌抗血清与测试菌株在玻片上混合,阳性菌株就会形成大的凝集颗粒。
- 流行病学
猪链球菌所致猪链球菌病在猪群的流行情况、发病及死亡率均有很大差异。英美等国的调查表明,发病率可以小于1%直至大于50%,但一般不超过50%,卫生条件差及存在并发感染时则导致发病率升高[12],我国的发病率虽无精确的统计,但据认为在暴发时可超过50%,流行一般持续数周。
任何日龄的猪均可感染,集约化猪场尤为严重。断奶及混群时期往往是发病高潮期。此病的传播途径很多,母猪可作为传染源,其子宫或产道可能带菌,仔猪可在出生前或出生时经产道感染;猪链球菌入侵门户通常为口、鼻腔而后在扁桃体定居繁殖,因此直接接触和飞沫传播也是一种途径;昆虫也可作为传播疾病的一种途径。
人的感染[16]是通过与病猪接触而传染上的,未发现人与人之间的传播。中国、泰国、奥地利等国有报道此菌致人脑膜炎等症状,病人有的死亡,有的经治疗后,虽没有生命危险,但却导致永久性耳聋等后遗症,病人大多直接与猪或野猪有接触,经皮肤伤口感染[13]。
一般认为在所有的血清型*猪种**链球菌2型是毒力最强的,也是从致病动物中分离率最高的。但是在不同地区,情况可能并不相同,如加拿大最近7年内猪链球菌2型在分离到的猪链球菌所有血清型中由22%下降到15%[14],而在法国70%的分离株为猪链球菌2型[12],在我国猪链球菌2型占大多数。可能的原因是北美洲和欧洲及亚洲等地区猪链球菌具有不同的致病力,而在定的条件下,其他一些血清型会表现出较高的致病力,如英国的猪链球菌14型[15],加拿大的猪链球菌5型[12]。
- 临床症状与病理变化
无论是何种链球菌感染[26],其症状都类似,即临床症状和肉眼病理变化与特定的血清型无关,但发病猪群呈现的临床症状各异。超急性病例,病猪不表现任何症状即突然死亡。急性病例中的临床症状主要是发热、抑郁、厌食,随后表现一种或几种以下症状,如共济失调、震颤发抖、角弓反张、失明、听觉丧失、麻痹、呼吸困难、惊厥、关节炎、跛行、流产、心内膜炎、阴道炎等。
超急性和急性引起死亡的猪通常没有肉眼可见的病变,败血症病例,全身脏器往往会出现充血或出血现象。部分表现为脑膜炎的病猪可见脑脊膜、淋巴结及肺发生充血。脑脊膜炎最典型的组织病理学特征是嗜中性白细胞的弥漫性浸润,其它的组织病理学特征包括脑脊膜和脉络丛的纤维蛋白渗出、水肿和细胞浸润。脉络丛的刷状缘可能被毁坏,脑室内可见纤维蛋白和炎性细胞。脉络丛上皮细胞、脑室浸润细胞以及外周血单核细胞中可发现细菌。
肺脏常呈实质性病变,包括纤维素出血性和间质纤维素性肺炎、纤维素性或化脓性支气管肺炎。部分病例有血管外周、支气管外周及细支气管外周的淋巴细胞套,支气管、细支气管炎,肺泡出血,小叶间肺气肿以及纤维素化脓性胸膜炎。因从猪链球菌感染的病猪肺内常分离出多杀性巴氏杆菌、胸膜肺炎放线杆菌等细菌,故部分学者认为,病猪肺部的病变可能与以上细菌的继发感染有关。
在关节炎的病例中,最早见到的变化是滑膜血管的扩张和充血,关节表面可能出现纤维蛋白性多发性浆膜炎。受影响的关节,囊壁可能增厚,滑膜形成红斑,滑液量增加,并含有炎性细胞。
心脏损害包括纤维蛋白性化脓性心包炎、机械性心瓣膜心内膜炎、出血性心肌炎。组织病理学变化为心肌发生点状或片状弥漫性出血或坏死、纤维蛋白化脓性液化。心包液中常含有嗜酸性粒细胞,少量嗜中性粒细胞及单核细胞,具有大量的纤维蛋白。
- 致病机理
猪链球菌病的致病机理尚不十分明了,大量的研究表明无论那种链球菌引致的猪链球菌病都与病原的毒力因子密切相关,业已证明,马链球菌兽疫亚种的主要毒力因子有荚膜、类M蛋白、金属结合脂蛋白、链激酶、IgG结合蛋白、纤维结合蛋白透明质酸酶等。猪链球菌2型的主要毒力因子有荚膜、溶菌酶释放蛋白(MRP)、胞外蛋白因子(EF)、猪溶血素和IgG结合蛋白等。
猪源链球菌感染猪后,首先定植在扁桃体中,部分猪逐步发展成为败血症,最终形成脑膜炎或关节炎。定植于扁桃体中的猪链球菌2型要进入机体的血液循环系统,必须首先突破扁桃体及上呼吸道的屏障进入血液循环系统。猪源链球菌能大量粘附于巨噬细胞表面而不被吞噬,因而血流中猪源链球菌可以粘附的形式被体内的吞噬细胞携至目的地,从而引起各种症状。
- 猪链球菌病诊断
根据流行病学、临床症状和病理变化等能对猪链球菌病作出初步诊断,确诊需病原的分离与鉴定。国内外现有的检测方法主要有三大类:分离培养及生化鉴定、血清学鉴定、分子水平鉴定。
从患病猪的病变组织如扁桃体、肺脏、肺门淋巴结、脾脏和脑组织等中较易分离到细菌,分离到细菌后,可进行细菌生化鉴定,但由于猪源链球菌的生化特征并不十分稳定,菌株间往往存在差异,因此应与血清学等方法结合起来。马链球菌兽疫亚种可用乳胶凝集诊断试剂盒进行诊断,猪链球菌2型可用相应的高免血清进行玻片凝集试验进行诊断。分子生物学方法已大量应用于该病的诊断, PCR是一种快速而特异的检测猪源链球菌的方法,国内外已建立了多种PCR诊断方法,如16S~23S rDNA特异序列、与马链球菌兽疫亚种和猪链球菌2型相关毒力基因的检测等。
- 防控措施
猪链球菌病的发生涉及诸多因素,如猪群的健康状况(如混合感染、免疫抑制),菌株毒力的大小,环境和管理的质量等。拥挤、通风不良、大幅度温度变化以及2周龄以上差异的猪流动、混合饲养都是易感猪发生猪链球菌感染的重要因素。全进全出的饲养管理方法,将大畜舍隔成小间,有助于减少猪群间的流动和降低温差变化。另外,适当的通风、控制虫害、清洁卫生、干燥适度的圈舍以及消毒剂的使用均可将该病的发生降低到最低限度。
免疫预防是控制的最有效手段,马链球菌兽疫亚种有商品化的弱毒疫苗,可用于该菌引起的猪链球菌病,但应考虑其安全性。猪链球菌2型尚无商品化的疫苗。由于猪链球菌病病原复杂,不同链球菌之间的免疫交叉性差,因此,根据我国的流行情况,研制马链球菌兽疫亚种和猪链球菌2型的二联疫苗是控制该病的关键。对感染猪源链球菌并出现临床症状的猪,敏感的药物、合适的给药途径有助于感染猪的康复。大多数分离株对青霉素、阿莫西林、氨苄青霉素等敏感 ,对四环素、林可霉素、红霉素、卡那霉素、新霉素、链霉素则具有高度的抵抗力。饲料中加入治疗剂量的抗生素有助于控制临床发病,但不能清除携带的病菌。应该注意的是链球菌对敏感药物易产生抗药性,在临床用药中应充分考虑,最好的方法是在药敏试验的基础上选择敏感药物进行治疗和预防。
- 材料和方法
- 材料病料来源
病料采集于洛阳周边县地区猪场病死猪的肝、肺脏、心血等组织(共23份病料)。病变特征通常为全身皮肤、浆膜、粘膜和内脏器官等有不同程度的出血。
- 培养基
胰蛋白胨大豆琼脂培养基(Tryptone soya agar, TSA;购自美国BD公司)。
- 仪器与实验试剂
培养皿、西林瓶、移液枪(Nichipet EX Autoclavable 日本)、电子天平(Sartorius BS210S)、超净无菌工作台(苏州净化设备公司)、电热恒温鼓风干燥箱(HH.BⅡ-1 长沙医疗器械厂)、恒温培养箱(上海市跃进医疗器械一厂)、高压蒸汽灭菌器(上海申安医疗器械厂)、高速离心机(上海安亭科学仪器厂)、光学显微镜、PCR仪、凝胶成像仪(Multilmage Light Cabinet IS2200美国)、冷冻干燥机(ALPHA 1-2 德国)、电泳成套设备等。
胰蛋白胨大豆琼脂,牛血清,烟酰胺腺嘌呤二核苷酸(nicotinamide adenine dinucleotide,NAD,又称V因子),革兰氏染色试剂组,PCR扩增所用的试剂组包括:10×Taq Baffer,Taq酶(2 U/μL),dNTP,大肠杆菌及链球菌引物各一对,超纯水。
- 方法猪的病料采集
病料来自于洛阳地区养殖户的病死猪,采病料前,先准备好灭菌剪刀、无菌塑料袋。采集对象为猪的肺脏及心血,采完后迅速接到琼脂平板上。
- 链球菌及其它细菌分离
首先需要制作培养基:用电子秤称取4 g TSA,加入100 mL蒸馏水混匀,115°C高压灭菌后待培养基降到一定温度,加入4 mL血清及100 µL NAD+轻轻混匀(整个过程在无菌台进行),倒入无菌平皿。
待冷却凝固后,用接种环沾取少许病料组织,在培养基表面进行平行划线或其它形式的连续划线,微生物将随着划线次数的增加而分离,经保温培养形成菌落,划线开始的部分细菌分散度小,形成的菌落往往连在一起;由于连续划线,微生物逐渐减少,划到最后常可形成单个孤立的菌落。观察平皿上菌落形态,找出形态各异的单个菌落进行染色。染色后即可通过观察分清链球菌及其它细菌的大致形态。
- 实验室常规鉴定
实验室常规鉴定一般通过染色镜检,观察菌落形态来判断,本实验采用革兰氏染色法。革兰氏染色法一般包括初染、媒染、脱色、复染等四个步骤,具体操作方法是:
1)涂片固定。在无菌操作条件下,用接种环挑取少量细菌于干净的载玻片上涂布均匀,固定。
2)草酸铵结晶紫染1分钟。
3)自来水冲洗,去掉浮色。
4)用碘-碘化钾溶液媒染1分钟,倾去多余溶液。
5)用中性脱色剂如乙醇(95%)或*酮丙**酸脱色,革兰氏阳性菌不被褪色而呈紫色,革兰氏阴性菌被褪色而呈无色。
6)用蕃红染液复染1分钟,显微镜观察革兰氏阳性菌呈紫色,革兰氏阴性菌则呈现红色。最后将所需的可疑菌落传代培养。
- PCR鉴定方法及过程
PCR(polymerase chain reaction,聚合酶链反应)是一种选择性体外扩增DNA或RNA的方法,它包括三个基本步骤:
1)变性(denature):目的双链DN*片A**段在94°C下解链。
2)退火(anneal):两种寡核苷酸引物在适当温度(50°C左右)下与模板上的目的序列通过氢键配对。
3)延伸(extension):在Taq DNA聚合酶合成DNA的最适温度下,以目的DNA为模板进行合成.由这三个基本步骤组成一轮循环,理论上每一轮循环将使目的DNA扩增一倍,这些经合成产生的DNA又可作为下一轮循环的模板,所以经25~35个循环就可使DNA扩增达106 倍。
- PCR反应的材料
1)引物:PCR反应产物的特异性由一对上下游引物所决定。引物的好坏往往是PCR成败的关键。
2)4种三磷酸脱氧核苷酸(dNTP):dNTP应用NaOH 将pH调至7.0,并用分光光度计测定其准确浓度。dNTP原液可配成5-10mmol/L并分装,-20°C贮存。
3)Mg2+:Mg2+浓度对Taq DNA聚合酶影响很大,它可影响酶的活性和真实性,影响引物退火和解链温度, 影响产物的特异性以及引物二聚体的形成等。
4)模板:PCR反应必须以DNA为模板进行扩增,模板DNA可以是单链分子,也可以是双链分子。
5)Taq DNA聚合酶:一般Taq DNA聚合酶活性半衰期为92.5°C 130 min,95°C 40 min, 97°C 5 min。现在人们又发现许多新的耐热的DNA聚合酶,这些酶的活性在高温下活性可维持更长时间。
表1 本试验所用的PCR引物
|
引物用途 |
引物编号 |
引物序列(5′—3′) |
PCR产物∕bp |
参考文献 |
|
鉴定链球菌 |
JP4 JP5 |
GCAGCGTATTCTGTCAAACG CCATGGACAGATAAAGATGG |
689 |
[20] |
表2 本试验PCR反应体系
|
本实验反应的体系:25 µL |
本实验反应的程序 |
|
10×Taq Buffer 2.5 µL |
95°C 4.0 min |
|
P1(上游引物) 1.0 µL |
95°C 0.5 min |
|
P2(下游引物) 1.0 µL |
55°C 0.5 min |
|
dNTPs 1.0 µL Taq聚合酶 0.5µL |
72°C 0.5 min 回到第二步进行25个循环 |
|
template 4 µL |
72°C 10min |
|
超纯水 15 µL |
10°C save |
- 电
前准备
1)配1×TBE电泳缓冲液300 ml胶浓度1.7%(100 mL 1×TBE加0.68 g胶)
2)微波炉中火2分钟溶解胶
3)冷却至60°C加入溴乙锭2 μL(10 mg/mL的终浓度0.5 μg/mL)
4)放入梳子,浇板,待凝固。
具体过程:接通泳槽电泳仪电源(注意正负极D*片A**段从极向正极移动),调节电压至60
80 V左右。当溴蓝料移动到离凝胶前沿1~2cm,停止电泳。取出胶块,凝像系统下进行观察
拍照。
- 细菌保藏与复苏细菌保藏
本实验采用冷冻真空干燥法,冷冻真空干燥法一般包括下面几个步骤:
1)脱脂牛奶溶液的配制:在电子秤上称取16 g脱脂牛奶,加入84 mL蒸馏水中混匀,装入玻璃瓶中。
2)所用的西林瓶充分洗净,三种规格的枪头、推种环提前准备好。
3)将上述物品放入高压锅121°C灭菌15 min。
将已灭菌好的脱脂奶溶液吸取8 ml加入到培养、生长丰富的菌体培养皿中制成菌悬液,在将悬液以无菌操作分装于灭菌的青霉素瓶中,每管约2 mL,盖好盖子冷藏于-70°C冰箱。冷藏一天后迅速转入提前10 min预热好的冷冻干燥机中,经过10~12 h后菌体已充分冻干,用封口膜封存后转入-20°C冰箱保存。
立式冻干机的操作规程:
1)严格遵守实验室的仪器设备管理制度,实行专人管理专人操作。
2)使用前,使用者应先提出申请,由管理员安排具体操作时间。
3)使用时,应查看前期记录,了解及其前期运转情况。
4)接通电源,在进气阀敞开情况下,打开真空泵开关,预热20~30 min(真空泵表面温度约70°C)。
5)打开冻干机预冷10 min,移开玻璃罩,放置样品(样品应预先在-20°C~-75°C预冷存)。
6)盖好玻璃罩,关闭放气阀,微通气阀,出水口和外挂接口。
7)打开通气阀,控制面板显示0.08 mbar,-56°C时,开始工作,当达到并稳定在0.06 mbar时,打开通气阀,直至样品冻干。
8)停止工作时,应先关闭外挂瓶阀门,去除外挂冻干样品。
9)关闭通气阀,再关真空泵,缓慢打开排气阀,适量进气,气压降至初始状态时,取出冷冻腔内样品,关闭压缩机。
10)去除冷凝管上的霜,打开出水口放水。
11)用品归位,仪器盖罩。
12)认真填写实验记录,仪器使用人员和管理人员签字。
使用过程中的注意事项:
1)仪器的开启和和关闭程序不能颠倒。
2)阀门的启开和关闭程序要清楚。
3)玻璃罩移开时应颠倒放置,以免揩去底部的封闭油。
- 复苏
过一段时间,随即挑取几瓶,在无菌操作台下,进行复苏检查菌株是否存活。
- 结果
- 链球菌的初步分离及分析
本次实验共收集23份病料,其中有21份皆能分离到呼吸道病原菌。通过整理发病猪的背景资料,发现若发病猪死前曾用过大量抗生素类药物,则培养基上基本不长菌。否则,会长菌。统计结果表明,从洛阳地区病死猪的肺脏、心血等组织中分离出了36株细菌,菌落形态各异(见图1),初步判定链球菌、大肠杆菌、葡萄球菌等较多。进一步通过革兰氏染色和PCR鉴定其中链球菌7株(表3),占19.5%。这表明链球菌在猪群的感染情况非常普遍,已经成为猪呼吸道的重要病原菌。
在36株菌体中,革兰氏阳性菌占19株,革兰氏阴性菌占17株,比值几乎为1:1。资料显示:不同细菌对不同类型的药物有不同的敏感度,如革兰氏阳性菌对β-内酰胺类药物的青霉素,阿莫西林等大多敏感,而对革兰氏阴性菌则要选用氨基糖苷类,喹诺酮类。因此,洛阳地区猪场应该注意在选药方面的比例搭配。
图1 猪肺脏分离细菌的原代平板
表3 链球菌的分离及鉴定结果
|
采 取 时 间 |
编 号 |
病 例 来 源 |
日 龄 |
症状及病理剖检变化 |
猪链球菌PCR |
|
2009.01.05 |
S0105 |
新安 |
30日龄仔猪 |
呼吸困难渐进性消瘦,眼睑水肿,耳部、体表皮肤发紫 |
- |
|
2009.01.06 |
S0106 |
新安 |
30日龄仔猪 |
体温时高时低,食欲不振,便秘与腹泻交替出现。全身皮肤、浆膜、粘膜和内脏器官有不同程度的出血 |
+ |
|
2009.02.20 |
S0220 |
宜阳 |
成年 公猪 |
出血性败血症,关节肿大及心内膜炎 |
+ |
|
2009.02.22 |
S0222 |
嵩县 |
60日龄 肉猪 |
呼吸急促而困难,腹部搧动,肺肿大,呈暗红色至紫红色其表面和胸膜之间有纤维素样附着, |
- |
|
2009.03.01 |
S0301 |
孟津 |
成年 母猪 |
精神沉郁、食欲不振或废绝,呼吸困难、喘气。肺肿胀、变硬;呈不能收缩的橡皮状肺 |
- |
|
2009.03.05 |
S0305 |
偃师 |
45日龄母猪 |
体温升高,呼吸困难,气喘、咳嗽和皮肤发绀。胸腔内有血性胸水,有的凝集成果冻状 |
- |
|
2009.03.09 |
S0309 |
涧西区孙其屯 |
45日龄 肉猪 |
体温时高时低,食欲不振,便秘与腹泻交替出现。全身皮肤、浆膜、粘膜和内脏器官有不同程度的出血 |
+ |
- 猪链球菌的分离结果及分析
感染猪的链球菌种类较多,不仅包括猪链球菌,还包括马链球菌兽医亚种、停乳链球菌类马亚种、牛链球菌等。其中猪链球菌是其最重要的病原菌,毒力也最强。在本次试验*共中**分离到7株链球菌,疑似菌株均通过实验室镜检和PCR方法进行鉴定。从图2中可以看到:链球菌呈链状排列,短者4~8个细菌组成,长者有20~30个细菌组成,革兰氏染色,链球菌被染成紫色。另外,通过革兰氏染色镜检判定的7株链球菌进一步通过猪链球菌的特异性引物(种特异性)进行PCR鉴定(图3),发现阳性的为3株,即猪链球菌。剩余的菌株有可能为其它链球菌,如马链球菌兽医亚种菌株等,由于没有特异性引物,没有进一步鉴定。
图2 链球菌在光学显微镜下的状态(100×)


图3 特异性引物对猪链球菌的PCR鉴定结果
‘-为阴性对照’
- 细菌的冻干与保藏结果
为了将分离的7株链球菌进行长期保藏,我们对这些菌株进行了冻干保藏。本次实验在操作过程中除了镜检受污染的和冷冻过程中出现气泡(放入冻干机之前菌体冷冻的温度过低)的之外,最终冻干状态良好的共26株细菌(3~4瓶/株)。图4显示的是某菌株冻干好的状态照片,冻干后,原来的液体变为固体状态,呈蓬松的蜂窝状结构,加水立即溶解。
李伯林、吴皖卿[22]对用冷冻真空干燥法保存了18年的脑膜炎双球菌、白喉杆菌、志贺菌、霉菌和不凝集性弧菌等比较容易死亡的细菌和真菌菌种进行活力测定,结果成活率都在90%以上,基本已达到100%。因此,冻干后的细菌可长期保存,一般可保存3~10年。

图4 部分菌株的冻干保藏
冻干好的细菌为了以后使用和查找方便,需要贴上标签,标签上应写上一些必要的信息,如菌种名称、保存时间、保人等,具体如图5。贴好标签后,将所有冻干细菌放置在-20°C冰箱保藏备用。
|
名称:S. suis |
|
时间:2009.04.13 |
|
保人:***(PCR已鉴定) |
图5 猪链球菌标签样本
- 讨论
- 病料来源的分析
由于链球菌广泛存在于正常猪的上呼吸道、扁桃体等器官和组织中,猪群链球菌的带菌率与猪群是否发生猪链球菌病并无直接关系[25]。本次试验在采集的17头病猪的过程中,只有1头是发生了猪链球菌病,其它的病猪所得的病分别为:3头患高热病,5头患猪蓝耳病,6头因患胸膜肺炎而死亡,2头猪是患猪瘟而死亡。在分离到的7株链球菌中除了感染链球菌的病猪外,在其它病猪中也分离到。另外,在采集病死猪的部位中,心血的细菌分离率最高,在血清平板上的菌落形态也比较多,其次是肺脏,最后是肝脏。分析认为这是由于病猪受感染后,内脏器官大都发生病变,心血可以到达大部分组织器官中。如果从心血中分离到链球菌,也就证明该病原菌已经造成的猪的全身感染,是导致其发病或者死亡的重要病原菌。
- 受检地区环境分析
从采集的病料来源来分析,我们可以得出:能从病死猪身上分离到这么多种类的菌株与养殖户养殖条件有很大联系。据了解,从洛阳周边地区所采集病料的养猪场,大都是个体小型养殖场,而小型养殖场也大都是存在技术力量弱,生产水平低;疫病发现晚,治疗不及时;环境质量差等问题。
我国规模化养殖的发展迅速,但在局部封闭的密集饲养环境下,猪对疾病的抵抗力会降低,这些都使得猪病容易发生,传染病因此有了很大流行潜力。同时农村散养殖户的养殖防疫体系落后,20世纪80年代初农户散养所占的比例为90%,规模化养殖量不到10%,虽然目前中国的养猪模式发生了巨大变化,规模化养殖量高达50%,农民散户养殖量下降到50%,但农村散养量所占比例仍然过大,农村散养户猪群仍是疾病主要传播源[17]。环境质量差就导致链球菌等病原菌无处不在,因为细菌广泛分布于水、土壤、空气、尘埃及动物与人的肠道、粪便、呼吸道、泌尿生殖道中,带菌者与患病者均为疾病的传染源。感染发病动物的排泄物、分泌物、血液、内脏器官及关节内均有病原体存在[18]。
- 流行病学数据分析
通过革兰氏染色和PCR鉴定其中链球菌7株,占19.5%。这表明链球菌在猪群的感染情况非常普遍,已经成为猪呼吸道的重要病原菌。有关学者对各地猪链球菌病的流行病学调查表明,目前各地该病的流行菌株已不仅仅局限于C群兽疫链球菌,D、E、L等血清群的链球菌也占有很大比例。1998年该病在江苏省大规模暴发,引起大批猪及少数人[23]死亡,经鉴定这次流行的猪链球菌病为R 群Ⅱ型链球菌,此前国内虽有该血清群猪链球菌病的报道,但因发生范围小,而未能引起重视。目前,用于该病免疫预防的疫苗主要是以C群兽疫链球菌为疫苗株的灭活疫苗或弱毒活疫苗,而与当地的猪链球菌病流行株并不相符,这正是猪链球菌病不能得到有效控制的主要原因。
- 猪病理变化分析
在采集的17头病猪中,大多出现全身皮肤、浆膜、粘膜和内脏器官等有不同程度的出血。全身淋巴结肿胀肝脏肿胀,扁桃体滤泡淋巴细胞坏死,后期淋巴结细胞增生。部分病死猪肾肿大,质地较脆,有瘀血现象。在这种病变情况下,细菌很容易繁殖,如大肠杆菌、链球菌、巴氏杆菌等。如果在这时不采取病猪隔离、掩埋等处理方法那就会导致整个猪场疾病流行,病菌相互感染。
从表3可以看到,在洛阳地区采集的病死猪中,病理变化大多都不相同,这是因为本次试验是从2008.12.28~2009.3.25阶段采集的,有些细菌病的发病季节可能会不一样
- 结论
本研究的结果表明,在洛阳及其周边地区的猪群中,链球菌的感染情况非常严重,在猪链球菌病的防治过程中应当给予重视。本研究为猪链球菌病的防治提供了理论数据;同时,为猪链球菌病快速诊断试剂与高效疫苗的研制、开发等提供了菌株材料。
参考文献
[1]Aarestrup FM, JorsalS E, J ensenN E, etc.Serologicalc haracterization and antimicrobial susceptibility of Streptococcus suis isolates from diagnostic samples in Denmark during 1995 and 1996 [J]. VetMicrobial, 1998, 60[1]:59-66
[2]Milan DU, C hoiC , HamH J, etc. P revalence, capsular type and a ntimicrobial susceptibility of Streptococcus suis isolated froms laughterp igsin Korea[J]. Can J VetRes, 2001, 65[3]:151-155
[3]Hommez J, Devriese LA, Castryck F, etc. Beta-hemolytic streptococci from pigs:bacteriologicald iagnosis[J]. ZentralblV eterinarmedB, 1991,3 8[6]: 441-444
[4]Katsumi M, Kataoka Y, Takahashi T, etc. Bacterial isolation from slaughtered pigs associated with endocarditis, especially the isolation of Streptococcus suis [J]. VetMedSci, 1997, 59[1]: 75-78
[5]黄毓茂,黄引贤.2型猪链球菌的血清学鉴定[J].中国兽医学报, 1995, 15[1]: 63-65
[6]姚火春,陈国强,陆承平.猪链球菌1998分离株病原特性鉴定[J]. 南京农业人学学报1999, 22[2]: 67-70
[7]马有智,方维焕,柯春林.猪链球菌2型分离株的生物学特性[J] .中国兽医学报,2003, 23[4]: 326-328
[8]许信刚,魏拣选,张琪等.猪链球菌2型的分离鉴定及免疫预防[J]. 动物科学与动物医学, 2003, 20[3]:21-22
[9]刘佩红,沈素芳,王永康等.上海地区猪源链球菌分离株的病原特性鉴定[J]. 中国兽医学报, 2001, 21[1]: 42-46
[10]倪宏波,王兴龙,兽会军等.长养地区猪源链球菌分离株的病原特性研究[J], 黑龙江八一农垦大学学报,2002, 14[1]:64-68
[11]杨霞,卢中华,张红英等.猪链球菌病病原的分离与分群鉴定[J], 河南畜牧兽医, 2003, 24[3]:7-8
[12]Straw BE,Allaire SD,Mengeling Wl,Taylor Dj(Eds).Diseases of Swine.Iowa State Eniversity press, Ames, 8th edition. 1999, 563-570.
[13] Holt JG, etal.1986. Bergey,s Manual of systematic Bacteriology Volumel.Baltimor- e/London:Williams﹠Wilkins
[14]Coetzer JAW.Thomson GR.Tustin RC.Infectious diseases of livestock.Oxford University Press, 1994, 1243-1260
[15]何家惠,诸长贵,徐药遐等.猪急性败血型链球菌的诊断及病原鉴定[J].中国人兽共患病杂志,1999, 15 [5]: 190-191
[16]冼卓礼, 陈毅斌.我国养猪业的现状和发展趋势[J].畜牧市场,2008,[3]:4
[17]王健.猪链球菌病及其防控[A] .第二届中国畜牧科技论坛论文集[C].重庆:2005.09.24.11
[18]Bej A K, McCarty S C, Atlas R M. Detection of coliform bacteria and Escherichia coli by multiplex polymerase chain reaction: comparison with defined substrate and plating methods for water quality monitoring[J]. Applied and Environmental Microbiology, 1991, 57: 2429-2432
[19]黄静,张苏强.猪溶血性链球菌诊疗报告[J] .中国兽医杂志,1992, 18[1]: 22-23
[20]OkwumabuaO,O’Connor M,Shull E. A polymer-ase chain reaction(PCR) assay specific for Streptococcus suis based on the gene encoding the glutamate dehydrogenase[J]. FEMS Microbiol Lett,2003,218(1):79-84
[21]何家惠,徐药遐,侯继波等.一起2型链球菌致猪急性败血症暴发流行[J].中国人兽共患病杂志,2000, 16 [1]:109
[22]陆承平,姚火春,杨汉春.兽医微生物学[M] .第三版.中国农业出版社.北京: 2001:290
[23]李伯林,吴皖卿.一种简便的菌种冷冻真空干燥保存法[J] .中国卫生检验杂志, 2000, 10(5):619-620
[24]蔡宝祥.家畜传染病学[M]. 第四版. 中国农业出版社. 北京:2006.95
[25]赵战勤,胡睿铭,吴斌等. 猪源链球菌的分离鉴定及生物学特性研究[J].畜牧兽医学报, 2007, 38(4): 7
外文资料翻译
猪链球菌:一个新兴的人畜共患病病原体
在全世界,猪链球菌是猪的主要病原体,它可以通过接触病禽而传送到正常人。猪链球菌在猪和人中可以引起髓膜炎、败血症、心内膜炎、关节炎和败血性休克,死亡率高。人感染猪链球菌主要发生在经常接触猪或猪肉的某些高危人群。虽然暴发人类猪链球菌感染是罕见的,但有几个疫情发生却在中国最近几年。2005年7月,最大的爆发人类猪链球菌感染疫情发生在四川,其中204人受到感染, 38人死亡。有四百零九个人类猪链球菌感染案件分布在世界各地,其中大部分发生在中国,泰国和荷兰,而这些感染已导致73人死亡。这次审查提供了关于革兰氏染色阳性细菌型病毒的分子特性的背景资讯和生物学,而且描述猪链球菌传染人的临床征状、病理学、流行病学、诊断和治疗。
引言
猪链球菌是一项重要的病原体,在病猪中大范围存在,包括脑膜炎、败血症、肺炎、心内膜炎和关节炎,可以直接传染给人类。第一个人感染猪链球菌的案例在 1968 年丹麦被报告。人感染猪链球菌已成为一个严重的人畜共患病,并已在许多密集养猪生产的国家流行。2005 之前超过 200个案例在全世界被报告, 其中大部分来自欧洲和亚洲国家和地区。
在 2005 年七月,四川省爆发了人感染猪链球菌,其他省份也有一些零星案件。这已是中国第三次爆发人类感染猪链球菌病疫情,前两次爆发是在1998年和1999年的江苏省。在过去的8年中,至少有237人感染猪链球菌和53人死亡。猪链球菌多次密集暴发已经引起了全世界上公众极大关注。
生物学特性
猪链球菌是一个革兰氏染色阳性兼性厌氧菌,球形或者卵形的,并出现成对或短链的单细胞。根据荚膜多糖, 35个血清型已确定(类型1-34和1/2) ,2型是猪和人感染疾病最常见的,也是全世界最常见的血清型。除了两列人因猪链球菌感染引起的案件是1型和败血症造成的14型,其他所有人的猪链球菌感染都是由于2型。
猪链球菌的自然栖息地是猪上呼吸道,尤其是大片猪的扁桃体、鼻腔以及生殖器和消化道。猪链球菌2型可以寄居腭扁桃体,临床看起来健康的猪,通常是从鼻腔或口头传播。猪链球菌的载体是猪链球菌感染猪和其它重要的是传播源。
猪链球菌2型抗各种环境条件,它可以在60 ℃存活10分钟,在50 ℃存活2小时,并在0°C-10°C的尸体中存活6个星期的,这个生物体可以在灰尘中存活1个月,粪便中存活3个月以上,而在 25 °C 时,它能在灰尘中存活24小时和在排泄物中 幸存8 天。然而,猪链球菌 2 型能在5% 漂*粉白**按1:799稀释中容易被杀灭。
猪链球菌敏感的抗生素,包括青霉素、头孢三嗪、头孢菌素、氨苄西林和阿莫西林。青霉素G是常用来治疗或控制猪链球菌引起的感染。然而,耐青霉素菌株已被分离,其他常用抗生素的高度耐药株也被报告。
猪链球菌的基因组已经完全地被序列,包含20074917碱基,41.3 %含量的G + C。虽然20-30 %的基因是未知的,但已知基因可能会对研究发病的而猪链球菌感染发挥作用,包括多糖生产、囊运输、铁制约因素、碎米桠素、毒力相关蛋白、各种酶、精氨酸deiminase系统和IgG结合蛋白。
在猪链球菌的毒力因子上研究猪链球菌已开始揭示这一细菌的致病机制。猪链球菌的毒力在相同的血清类型以及不同类型之间是不一致的。大多数研究猪链球菌毒力因子与毒力血清型2已进行了描述,包括胶囊、溶菌酶释放蛋白和胞外蛋白因子,碎米桠素和黏附素。
鉴定
猪链球菌能够在无氧或者有氧的情况下生长,但无法在6.5 % NaCl溶液增长。猪链球菌的菌落是小的(0.5-1.0 毫米直径)、带灰或透明的,略有黏液。最多的猪链球菌类型出现在溶血绵羊血琼脂板上的α窄带。猪链球菌2型的α带β带分别出现在溶血绵羊血琼脂平板和溶血的马血琼脂板。以四个生化检验(Voges-Proskauer 、柳糖、海藻糖和 6.5% NaCl)为基础,可对几乎所有猪链球菌的囊类型成功识别。然而,生化特性往往很难确定,可能需要结合生化反应,其次是确定血清型。后一种方法是根据利用荚膜多糖抗原的而产生的多个方法:囊反应,7-11 , 51毛细管沉淀或共同凝集试验。
PCR是明确动物载体中猪链球菌的特定血清类型,或确定健康猪被菌株感染,甚至病人临床诊断或流行病学研究的一种快速检测技术。PCR技术可对猪链球菌特异性的16S核糖体RNA (核糖核酸)地区和物种特异性探针,针对16S rRNA基因的基础上可用于识别猪链球菌株。以猪链球菌类型 2 的氨酸盐去氢136 基因 (gdh)里面的688 bp 碎片为基础的一个 PCR 步骤,被指出可以有效率地测试所有的猪链球菌类型。此外, 免疫捕获法,荧光抗体技术,全细胞抗原的间接ELISA法,并纯化荚膜多糖抗原为基础的间接ELISA60已经制定出来。
以 16S rRNA 基因的顺序为基础,35个血清类型的亲缘分析和60个伴侣基因的能活区域也可显示,血清类型 32 和 34是远端其它血清类型,而且被确认为 S orisratti 了。限制性片段长度多态性、基因组指纹图谱和多位点序列分型等分子方法已被用来研究遗传多样性的猪链球菌株,特别是同本生物的致病性克隆。
人的感染的临床征状
人类感染猪链球菌是最常见的表现是化脓性脑膜炎,但感染性休克与多器官功能衰竭、心内膜炎、肺炎、关节炎、腹膜炎也已报告。在感染猪链球菌的患者之中,临床征状都有所差异,以急性形式的髓膜炎为主。症状包括高热、头痛、恶寒、恶心、呕吐和眩晕,并且接连出现听力损失、散步运动失调、昏迷、颈部僵硬、瘀点、关节疼痛、周围和面瘫、严重肌肉疼痛、瘀斑、皮疹。急性毒性形式的感染性休克,除了发高烧、发冷、头痛、呕吐、眩晕、腹痛,其他临床症状如低血压、心动过速、肝功能障碍、皮下出血、弥漫性血管内凝血、急性肾功能衰竭、急性呼吸窘迫综合征。听力损失是最常见的后遗症恢复为化脓性脑膜炎,而往往因休克死亡。
病理学
对受到猪链球菌传染的猪中有病理、组织病理学说病变的许多描写,最常见的病变是严重的脑膜充血、淋巴结、肺和在病理组织学发现的脉络膜丛。在中枢神经系统,可以看到相关性病变的脑膜炎和脉络膜炎,包括水肿的软脑膜和硬脑膜,急性链球菌猪脑膜炎最具特色的病理病变的是一种弥漫性渗透。增加数额脑脊液中也出现了在髓膜炎被腰椎穿刺的人的案例报告。通过尸检检查患者死于感染性休克综合征或脑膜炎综合征,其中包括广泛的出血,尤其是在胃和肾上腺,脑膜充血,水肿的大脑,心肌充血,弥漫性血管内凝血,缺乏凝血全血,以及败血症。此外,观察变性或坏死的肝细胞和肾细胞,病理特征与病猪和患者类似。
流行病学
猪链球菌分布在世界各地,是最适合家养的猪,但偶尔也从野猪、马、狗分离到。猪链球菌 2 型可感染猪 结肠 、腭扁桃体却看起来健康的猪。因此,无症状的载体可以表现对兽群或人的一个潜在感染来源。小猪仔最易感,但是感染能在任何的年龄发生(例如,劣质的住家环境却用不充分的供氧)。如果猪造成的压力变大和随后的免疫抑制的条件下,这种情况可进一步恶化。人类感染的原因主要是直接接触受链球菌感染的载体猪,病猪或含有通过伤口皮肤或粘膜的嘴和鼻腔感染猪链球菌的生猪肉。因此,人类感染通常发生在与其工作有关的,如猪农、屠宰场工人、肉类加工工人和兽医。这些人的感染率估计已经比一般大众高1500 倍之多。在某些情况下,猎人被感染时,会接触到野猪。被抑制免疫的个人,包括已经移除的脾的人,危险性在增加。所以,人的猪链球菌感染已经是在一些发达国家的人中当做一个职业病的看法。
猪链球菌通常不会引起人类感染的爆发,零星的病例报告也只在许多国家密集的养猪业。在第一例人感染猪链球菌的描述丹麦于1968年,迄今为止,大多数人类感染病例发生在欧洲和亚洲北部,全球案件总数超过400个,中国,泰国和荷兰的病例分别为69 % , 11 %和8 %。1998年和1999年夏季,江苏省农村地区爆发两个大的人类受感染的报告。25个报告的案件中, 14人死于感染性休克综合征和脑膜炎。2005年7月,暴发最大的猪链球菌人感染发生在四川省。由于缺乏及时的病例报告和规范的治疗,此次疫情造成204人感染和38人死亡,同时播及其他省份和地区,其中包括4名(1个死亡)在广东省和10个在香港。
在四川省和江苏省暴发这两起人类感染猪链球菌在 2005 年已经被数个的组报告。经过仔细的流行病学调查分析,这些疫情已经密切相关到一个爆发的猪链球菌感染的猪上,因为所有的233人的案件在流行地区的猪发生感染,,估计在那个时候这个省被感染猪链球菌的猪大约有80 000只。历史上几乎所有的人类患者都直接接触受感染的猪或猪肉。在205例调查中, 199 (97%)曾接触病猪,并在这199例, 134例(67 %)已屠宰病猪和100例(50%)有皮肤接触。在另外的一个报告中 Du 和 colleaguesmentioned 等八个人吃了不舒服猪的烹调良好的猪肉却没有临床征状,这表明人吃煮熟的猪肉不太可能有被传染的危险。在江苏、四川爆发的人类猪链球菌感染的这两个省份没有人对人的传染发生,人对人传染是不太可能发生不十分密切接触受感染的材料,如感染血液。迄今为止,在中国暴发这些所有的流行病学的考察数据表明,直接接触病猪是猪链球菌感染重要途径。
诊断和治疗
推测诊断人类猪链球菌感染是根据临床症状和微观病变,确认感染是通过隔离传染因子和辨认微观病变组织为基础的。根据流行病学史,如直接接触病猪的信息,对最后确认非常有益的。详细的临床症状和微观病变已经在前几节讨论了。此外,临床资料是最初的常规实验室检查并诊断疾病必不可少的。感染猪链球菌可显示高白细胞计数:13.8 -26 6 × 10 9 / L的( 81-95 % ,中性粒细胞)和高C -反应蛋白浓度130-236毫克/升(正常值﹤10毫克/ L )。在某些情况下,因为肝脏损害,可检测到高活动的谷丙转氨酶和谷草转氨酶。查病人的细胞集落刺激因子通常显示浊度,伴随着脑脊液(淋巴)细胞增多 (白细胞计数的1.25-3.24× 10 ⁹ / L ),和非常低浓度的蛋白质、葡萄糖、革兰氏染色法的脑脊液、血液、有时关节液,能显示革兰氏染色阳性的双或短链球形。隔离感染猪链球菌包括生化及血清学的程序,有时通过分子技术。2型特异性PCR程序,可以检测出已报告的感染人的猪链球菌。
链球菌对许多抗生素很敏感,一旦核实感染猪链球菌,及时用抗生素治疗,同时配合其他相关的治疗是非常有效的。治疗的患者之间的差异,取决于临床症状。在确认感染之后,病人的治疗,常用青霉素G ,伴随着一个或其他多个抗生素,包括头孢曲松,庆大霉素,氯霉素,和氨苄西林,抗生素的剂量因病情而异。对于不严重的患者,每6小时静脉注射400万单位的青霉素或每12小时2克头孢曲松,至少在10天内是有效的。对于在严重的情况下,每6小时静脉注射的2克头孢曲松,每个小时的2克头孢曲松并不总是有效的,通常对多种抗生素都一样。用抗生素治疗,其中的2克头孢曲松,6克氨苄青霉素和240毫克庆大霉素, 14天的治疗对51岁的男子和他的同事张治疗22例静脉注射高剂量的青霉素G(12-14百万个单位),地塞米松10 – 15毫克每天结合氯霉素或其他抗生素。对于发展为严重败血性休克的患者,抗生素已经失去了治疗效果,必须精心照顾和治疗,维持血糖浓度4-6 mmol / L,选择消化道除污战略,以防止医源性感染。感染性休克综合征可能会导致严重的损害器官,包括肝脏,肾脏和血液循环系统,因此,必须静脉注射免疫球蛋白。尽管做了适当的治疗但死亡率仍高(超过70 % )。
预防和控制
由于主要传染源是病猪,防止传染给人类,取决于控制患病动物。已经开发出来不同类型的疫苗,用于猪可产生不同的保护效果。接种净化的囊疫苗未能保护由猪链球菌2型感染的猪。用猪链球菌2型免疫小鼠纯化疫苗是完全免受病毒的挑战。但是,这种疫苗在其他实验中不能有效地保护疫苗对猪链球菌2型。接种病毒,弱毒,或福尔马林造成致命的猪链球菌2型变异的结果。疫苗普遍使用的在猪业中,但仍然是病猪分离的毒性菌株而产生的自体灭活疫苗,一个不利之处是自体疫苗缺乏安全性和有效性的数据。因此,每一批新的自体疫苗应该尝试对动物尝试和批判性评估,才能使用在更大的规模上。虽然使用灭活疫苗有局限性,但是这种疫苗能够保护由猪链球菌感染的健康猪,并防止这一疾病在畜群中暴发的猪链球菌感染而传播。
暴发的人类猪链球菌感染主要发生在低收入国家的集约化生产。在这些国家中,忽视了猪链球菌感染猪而受到损害,因为穷人畜牧业的条件单一,包括肮脏、潮湿、通风不好的住房,和被污染的饮用水或食物。因此,改善养猪条件和有效的接*猪种**疫苗方法,以减少爆发猪链球菌感染,而这反过来又降低了风险和人力传染。在目前,还没有人的猪链球菌疫苗。因此,在疫情严重的情况下,严格控制动物交易和屠宰是制止传播给人类的猪必不可少的措施。此外,日益认识到这种疾病处于高风险的预期也将有助于避免人类感染。应该对每个人准备长期教育,注意烹调猪肉,包括正在他们的家中这么做的人。当处理生或者未煮过的猪肉时候,那些用因磨损而有裂口的手套,而且准备猪肉的所有的人应该在接触之后彻底地洗他们的手,他们的器具。胜任的烹饪也是本质的。世界卫生组织建议,煮熟的猪肉应达到内部温度为70 °C或直到果汁是明确的,而不是粉红色。
结论
猪链球菌是一种日益重要的病原体,可以引起猪和人类脑膜炎,败血症,关节炎,心内膜炎,感染呼吸道,尤其是猪扁桃腺。猪链球菌的载体在兽群里面的传染途径中扮演重要角色,包括人。虽然猪链球菌毒力因子尚未得到确立,已经制定可以用各种方法来确定猪链球菌,包括生化,血清学,分子,以及其他技术。这些方法有助于确定感染剂,可以帮助人们迅速采取措施,控制在猪和人类感染猪链球菌的疫情。
目前人感染猪链球菌的各种临床症状表现最常见的是人感染化脓性脑膜炎,这是一些病人发生感染性休克死亡率高的原因。往往发现患者的病理变化类似于猪,因此快速诊断和适当的治疗是至关重要的,以减少猪链球菌对患者所造成的损害,目前抗生素的治疗是有效的相关措施。
人偶尔发生猪链球菌感染已经在全世界被报告,然而,人感染爆发是稀少的。在中国的最近人猪链球菌感染爆发可能由下列因素所引起:( 1 )穷人养猪的房屋,使猪容易受到猪链球菌疫情;( 2 )猪农或屠夫直接接触了病禽猪或生猪肉; ( 3 )吃了未煮熟的病猪肉;( 4 )延误诊断和治疗; ( 5 )高度株猪链球菌2型参与暴发;和( 6 )政府部门对贫困者之间的协调与合作应负责。
阻止人感染猪链球菌的的关键是避免与病猪或受传染的载体猪的直接接触。对于高风险群体,与病人密切接触的猪或生猪肉,佩戴手套和口罩是必不可少的。在流行地区,教育和人力链球菌猪链球菌感染是有助于提高人的猪链球菌感染在患者和医生。在猪和人感染猪链球菌方面逐渐增加的教育上有助于提高患者和医师的注意。